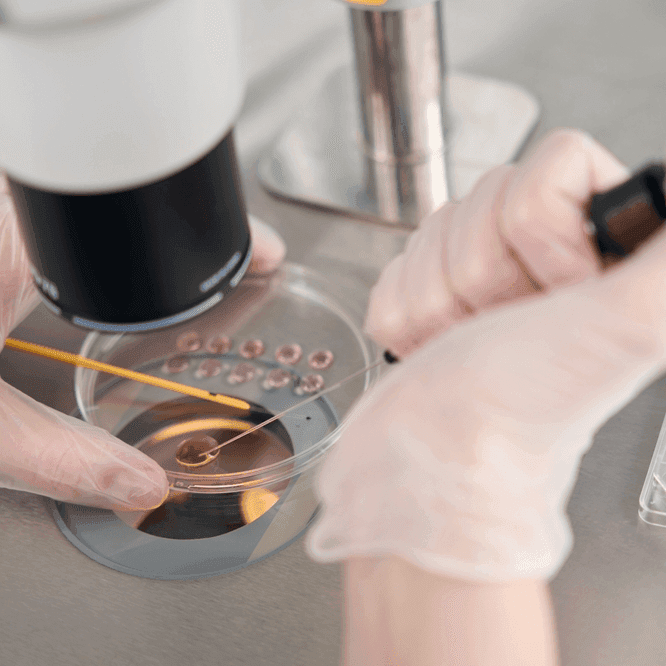
podcast image

Brain Waves: Scientists Make Breakthrough in Creation of Synthetic Human Embryos
Brain Waves: Scientists Make Breakthrough in Creation of Synthetic Human Embryos
Recommended
Guest: Dr Azlina Ahmad Annuar, Neurogeneticist
An embryo is formed as a result of the fertilisation of an egg by a sperm, and that’s what goes on to develop into a foetus. But what if an embryo could be created using only stem cells instead, sidestepping the need for eggs or sperm? That’s what a team from the University of Cambridge and the California Institute of Technology said they’ve successfully done. Here to help us understand what exactly these scientists have created and the ethical issues with these kinds of research, is neurogeneticist Dr Azlina Ahmad Annuar, joining us as always for her Brain Waves series.
Image Credit: Shutterstock
Presenter: Lim Sue Ann
Producer: Lim Sue Ann
Share:
Recommended



Recent episodes
0
Latest stories






BFM 89.9
The Business Station
Copyright © 2025 BFM Media Sdn. Bhd. 200601017962. All rights reserved
Copyright © 2025 BFM Media Sdn. Bhd. 200601017962. All rights reserved